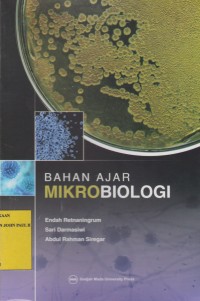
Image of Bahan Ajar Mikrobiologi

Text
Bahan Ajar Mikrobiologi
Buku ini membahas mengenai konsep dasar teoretis mikrobiologi dasar, hakikat studi keanekaragaman dunia mikroba sebagai pengantar dalam mempelajari cabang ilmu mikrobiologi berikutnya, baik dalam bidang mikrobiologi industri, kesehatan, lingkungan dan lain sebagainya.
Ketersediaan
| AKJP1765S | 579 END B | My Library | Tersedia |
| AKJP2287S | 579 END B | My Library | Tersedia |
| AKJP2288S | 579 END B | My Library | Tersedia |
Informasi Detail
- Judul Seri
-
-
- No. Panggil
-
579 END B
- Penerbit
- Yogyakarta : Gadjah Mada University Press., 2017
- Deskripsi Fisik
-
xvi; 151 hlm; 23 cm
- Bahasa
-
Indonesia
- ISBN/ISSN
-
978-602-386-175-0
- Klasifikasi
-
579 END B
- Tipe Isi
-
text
- Tipe Media
-
-
- Tipe Pembawa
-
-
- Edisi
-
-
- Subjek
-
-
- Info Detail Spesifik
-
-
- Pernyataan Tanggungjawab
-
-
Versi lain/terkait
Tidak tersedia versi lain
Lampiran Berkas
Tidak Ada Data
Komentar
Anda harus masuk sebelum memberikan komentar
 Karya Umum
Karya Umum  Filsafat
Filsafat  Agama
Agama  Ilmu-ilmu Sosial
Ilmu-ilmu Sosial  Bahasa
Bahasa  Ilmu-ilmu Murni
Ilmu-ilmu Murni  Ilmu-ilmu Terapan
Ilmu-ilmu Terapan  Kesenian, Hiburan, dan Olahraga
Kesenian, Hiburan, dan Olahraga  Kesusastraan
Kesusastraan  Geografi dan Sejarah
Geografi dan Sejarah